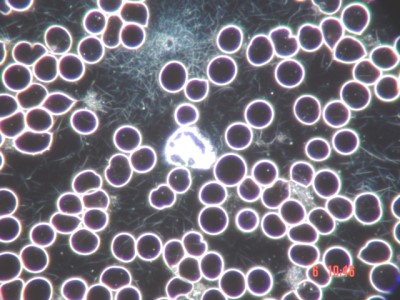
filitbildung

Acid StressAlmost every biological process in the human body depends on the acid-base balance of extracellular fluids (1). “Modern Western nutrition” produces a chronic subliminal metabolic acidosis (2). With increasing age the kidney function deteriorates. Therefore, the seriousness of this diet-related acidosis increases further (3,4).
Iridology (“cotton wool” acid ring) and darkfield image (fibrin) indicate acid stress of tissues. Images © Dr. Hilbert Seeger Today’s typically Western diet leads to an overproduction of non-carbonate acids. This is due not only to the high content of animal protein in this diet, but also to a high proportion of cereal products and a relatively low proportion of hydrogen carbonate-producing plant dietary components (5,6,7,8). Although the diet of our forefathers also contained high levels of meat, it did lead to the production of hydrogen carbonate by metabolism because it was also very rich in fruits and vegetables (8,9). Accordingly, the natural evolution of mankind was to excrete large amounts of hydrogen carbonate and potassium, rather than the large amounts of acids produced by today’s Western diet. The human kidney is not able to completely cope with the acid load that is frequently encountered nowadays (4,5,7,10). However, the resulting unexcreted acid does not titrate the plasma hydrogen carbonate until the concentration continues to decrease. In fact, this concentration remains in the lower normal range. The reason for this is that the undissolved hydrogen ions not only interact with sodium and potassium of the bone substance, but are neutralized by their basic salts (6,11,12). Although this prevents the development of a clearly visible acidosis, this acid titration of calcium-containing carbonates and hydroxyapatites leads to a mobilization of the calcium in the bones and thus dissolves the basic bone substance over time (6,11,12,13,14). This type of buffering of food-induced acidity can be considered a biological compromise (15,16), but leads to osteoporosis. In plain English this means that you do not necessarily have to be treated in an intensive care unit for metabolic acidosis to suffer from it.
The blood plasma is the extracellular space (“Pischinger Space”) of the blood. Dark field microscopy is an excellent instrument to assess the homeostasis of the blood and the tissue. The acid-base balance of the blood plasma (=extracellular space of the blood) is kept constant at a pH between 7.38 and 7.42. Author:
|